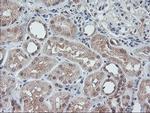
FMR1 Antibody in Immunohistochemistry (Paraffin) (IHC (P))

Search
OriGene
FMR1 Monoclonal Antibody (OTI2C3), TrueMAB™
{{$productOrderCtrl.translations['antibody.pdp.commerceCard.promotion.promotions']}}
{{$productOrderCtrl.translations['antibody.pdp.commerceCard.promotion.viewpromo']}}
{{$productOrderCtrl.translations['antibody.pdp.commerceCard.promotion.promocode']}}: {{promo.promoCode}} {{promo.promoTitle}} {{promo.promoDescription}}. {{$productOrderCtrl.translations['antibody.pdp.commerceCard.promotion.learnmore']}}
产品信息
TA504293
种属反应
宿主/亚型
分类
类型
克隆号
抗原
偶联物
形式
浓度
规格
纯化类型
保存液
内含物
保存条件
运输条件
靶标信息
FMR1 binds RNA and is associated with polysomes. The protein may be involved in mRNA trafficking from the nucleus to the cytoplasm. A trinucleotide repeat in the 5' UTR is normally found at 6-53 copies, but an expansion to 55-230 repeats is the cause of fragile X syndrome. Expansion of the trinucleotide repeat may also cause one form of premature ovarian failure. Multiple alternatively spliced transcript variants that encode different protein isoforms and which are located in different cellular locations have been described for this gene.
仅用于科研。不用于诊断过程。未经明确授权不得转售。
篇参考文献 (0)
生物信息学
蛋白别名: FMRP; FMRP translational regulator 1; fragile X mental retardation 1; fragile X mental retardation protein 1 homolog; fragile X mental retardation syndrome 1 homolog; fragile X mental retardation-1 protein; Fragile X messenger ribonucleoprotein; Fragile X messenger ribonucleoprotein 1; mFmr1p; MGC87458; Protein FMR-1; ragile X mental retardation protein; synaptic functional regulator FMR1; unnamed protein product
基因别名: Fmr-1; FMR1; FMRP; FRAXA; POF; POF1
UniProt ID: (Human) Q06787, (Rat) Q80WE1, (Mouse) P35922
Entrez Gene ID: (Human) 2332, (Dog) 481070, (Rat) 24948, (Mouse) 14265